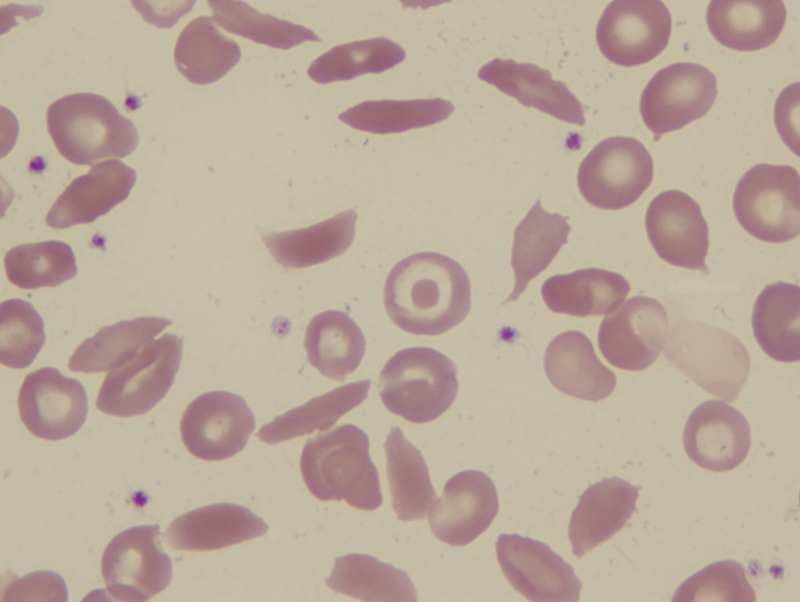

Transition to adulthood often accompanied by fragmentation of care for SCD patients
American Society of Hematology Annual Meeting Press Release Dec 11, 2019
Consistent, coordinated medical care can help prevent complications from complex conditions such as SCD. However, a new study found that most young adults with SCD – 78% – were admitted to multiple care facilities, fragmenting their medical care. By contrast, more than half –60% – of children with SCD received care at just one facility, suggesting fragmentation begins during the transition from adolescence to early adulthood.
“There are more people who are working to bring children into the health care system, whereas when people get older it becomes something they have to manage for themselves,” said senior study author Anjlee Mahajan, MD, of the University of California, Davis School of Medicine. “Young adulthood is often a period of transition; they might move to a new town or city and there are often shifts in health insurance. That point is when their care gets fragmented.”
The researchers analyzed health records of nearly 7,000 people with SCD who visited medical centers in California between 1991-2016. They divided patients into three age groups each covering a seven-year span from age 10-17 (childhood), 18-25 (young adulthood) and 26-33 (adulthood). Roughly one in five young adult or adult patients were admitted to five or more hospitals over just seven years.
The data revealed a stark shift in which patients went from receiving care at one or two facilities in childhood to over half of patients receiving care at three or more facilities after age 18. This fragmentation did not resolve as patients reached their late 20s and early 30s. Patients lacking health insurance, those visiting the hospital more frequently, and those who did not always receive care at specialized SCD centers tended to have the most fragmented care.
Based on the study, it is unclear how fragmentation affects patient outcomes, Dr. Mahajan noted. Patients who were more frequently admitted to the hospital overall faced the highest risk of death. About a quarter of young adult patients were admitted 30 or more times over a seven-year time period, an average of more than four hospitalizations per year. While fragmentation of care was associated with a higher frequency of visits, care fragmentation was not independently associated with increased risk of death.
Given that SCD requires active management to prevent pain crises and long-term organ damage, Dr. Mahajan suggested future studies could help identify the impacts of fragmentation and perhaps point to ways to support more consistent care throughout the transition to adulthood.
This article is a news release from American Society of Hematology Annual Press Meeting. Read the original here.
-
Exclusive Write-ups & Webinars by KOLs
-
Daily Quiz by specialty
-
Paid Market Research Surveys
-
Case discussions, News & Journals' summaries